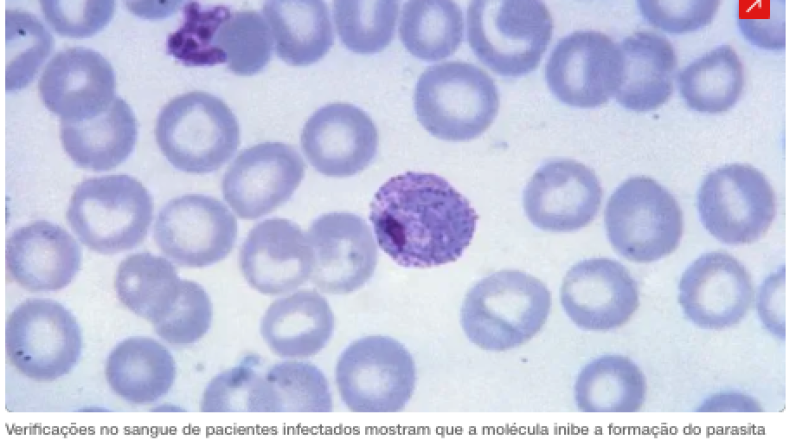
Captura de Tela 2026-02-11 às 11.13.35

A abordagem multiestágio consiste em uma estratégia mais completa para o combate à doença.
“Um diferencial importante desse composto é sua eficácia contra o Plasmodium vivax, espécie predominante no Brasil e que não é possível cultivar de forma contínua em laboratório. A descoberta foi possível graças a testes realizados na Fiocruz de Rondônia, com sangue de pacientes infectados. A molécula também atua contra o P. falciparum, espécie mais agressiva da doença”, afirma Anna Caroline Aguiar, professora da Unifesp (Universidade Federal de São Paulo) e autora do estudo.
O trabalho, realizado na Unifesp, teve a colaboração de integrantes do CIBFar (Centro de Pesquisa e Inovação em Biodiversidade e Fármacos), um Cedip (Centro de Pesquisa, Inovação e Difusão) da Fapesp sediado no IFSC-USP (Instituto de Física de São Carlos da Universidade de São Paulo).
A pesquisa também contou com o apoio da Fapesp por meio de Projetos Temáticos (21/12394-0 e 24/04805-8) e Bolsa Jovem Pesquisador, além da parceria da Fundação Oswaldo Cruz em Rondônia, do Centro de Medicina Tropical em Rondônia, da Universidade Nova de Lisboa em Portugal e da Universidade Federal de São Carlos.
No artigo publicado na revista ACS Omega, os pesquisadores descrevem o efeito triplo do composto, derivado de 4-quinolonas naturais, que bloqueia a infecção assexuada hepática, combate os estágios sanguíneos da doença (responsáveis pelos sintomas) e impede a transmissão ao mosquito.
“Estudamos esse composto há cinco anos e, ao longo desse tempo, comprovamos seu efeito contra o parasita nas fases hepática e sanguínea, em que ele está no hospedeiro. Neste novo artigo, é a primeira vez que demonstramos de modo experimental sua ação em bloquear a transmissão da doença”, afirma Aguiar à Agência Fapesp.
Os testes realizados em cultura celular com sangue de pacientes infectados mostraram que a molécula inibe a formação do parasita em estágios que ocorrem dentro do mosquito vetor (quando está nas fases denominadas oocinetos, oocistos e esporozoítos).
Dessa forma, mesmo que o inseto pique uma person infectada tratada com o composto, ele não consegue transmitir o protozoário para outra pessoa.
A análise foi confirmada em estudos realizados em camundongos na Universidade Nova de Lisboa. Os animais foram tratados com o composto e infectados com o Plasmodium berghei, espécie que infecta roedores.
“O que torna essa molécula especialmente interessante é que ela atua nas três fases do ciclo da malária: hepática, sanguínea e de transmissão. Em geral, o paciente com malária precisa de diferentes medicamentos para cobrir essas etapas e esse composto reúne potencial de tratamento e de bloqueio da transmissão, com possível uso para prevenção”, afirma Aguiar.
Muitas fases
A malária é uma doença complexa causada por protozoários do gênero Plasmodium, cujo ciclo de vida envolve dois hospedeiros: o ser humano e as fêmeas do mosquito Anopheles. No hospedeiro humano, esse ciclo se divide em três fases principais, conhecidas como hepática, sanguínea e de transmissão.
A doença começa nos humanos quando um mosquito infectado pica uma pessoa e injeta os parasitas, em forma denominada esporozoítos. Estes alcançam a corrente sanguínea e vão até o fígado da pessoa infectada, onde invadem as células hepáticas e se multiplicam.
Depois de se multiplicarem na fase hepática, os parasitas retornam à corrente sanguínea para invadir as hemácias (glóbulos vermelhos), destruindo-as. É nessa fase (denominada sanguínea) que surgem os sintomas típicos da malária, como febre, calafrios e anemia.
Já a fase de transmissão ocorre quando outro mosquito pica uma pessoa infectada e ingere os parasitas presentes no sangue desse indivíduo. Dentro do mosquito, eles se desenvolvem até atingirem a forma capaz de infectar outros humanos, reiniciando assim um novo ciclo.
Aguiar explica que a nova molécula atua na mitocôndria do parasita, inibindo um complexo enzimático denominado citocromo bc1, essencial para a produção de pirimidinas, blocos fundamentais do DNA. Sem a capacidade de formar DNA, o Plasmodium não consegue se replicar nem completar seu ciclo de vida.
“Outro aspecto importante é que essa molécula é altamente seletiva. Atua nas mitocôndrias do parasita, mas não nas dos humanos”, celebra Aguiar.
Os pesquisadores ressaltam que ainda existe um longo caminho até que a nova molécula se torne um fármaco capaz de combater a malária. Atualmente a doença mata cerca de 600 mil pessoas por ano, sendo a grande maioria no continente africano.
“A molécula é uma excelente candidata. Os indícios [de eficácia] justificam o investimento para o desenvolvimento futuro de um medicamento. Isso porque, embora exista tratamento para a doença, trata-se de um parasita muito bem adaptado e capaz de desenvolver resistência aos medicamentos existentes”, afirma Rafael Guido, professor do IFSC-USP e coautor do estudo.
O artigo Evaluation of the activity of 4-quinolones against multi-life stages of Plasmodium spp. pode ser lido aqui.
FONTE : CNN BRASIL POR Maria Fernanda Ziegler, da Agência Fapesp06/02/26 às 08:39 | Atualizado 06/02/26 às 08:39 em https://www.cnnbrasil.com.br/saude/composto-sintetico-tem-potencial-para-tratar-malaria-e-evitar-transmissao/